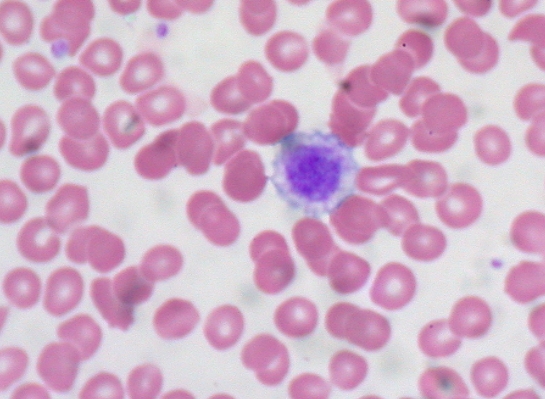
혈소판
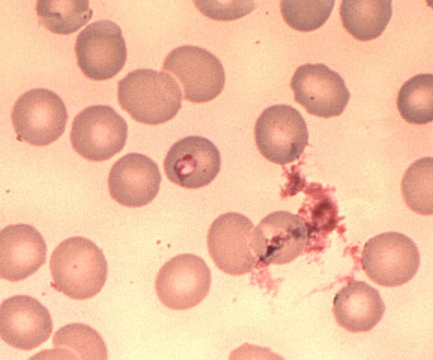
혈소판

혈소판 정상수치 기준에서 벗어나면 어떤 증상이 나타날까


혈액검사를 하면 여러가지 수치들이 쫘르륵 나옵니다. 그리고 높으면 H, 낮으면 L 이라는 단어가 옆에 표시됩니다. 그 중에서 오늘은 Platelet, PLT로 표시되는 혈소판 정상수치 그리고 그 기준에서 벗어나 H 또는 L로 표시되는 경우 어떤 증상이 나타날까 확인해 보도록 하겠습니다.
일반적으로는 혈소판 감소증 등으로 검색해 보는 분들이 많습니다만, 혈소판 수가 너무 높아도 이 또한 문제가 될 수 있으므로 기본적인 정상수치 파악과 어느 정도 기준에서 벗어나야 문제가 되는지도 확인해 두면 도움이 될 것입니다. 저는 항상 높게 나와서 문제이긴 하지만 의사선생님들도 너무 심하게 높은 것은 아니므로 말을 해 주진 않았습니다. 그래서 궁금해서 제가 알아본 정보입니다.
혈소판이란
혈액의 응고를 돕는 혈액 내의 작은 세포를 말합니다. 골수에서 생성되어 비장에서 저장되고 있습니다. 이 혈소판은 상처가 난 혈관을 폐쇄시켜 피브린이 혈병을 만든느 표면을 제공합니다. 혈액응고 형성에 필수인 응고인자 제공 및 매개하는 역할을 합니다.


혈소판 정상수치
혈액 1㎣에 15만~40 또는 15만~45만으로 말해지고 있습니다.
이 정상수치 기준에서 벗어나면 혈소판 이상이라고 하며 이는 혈소판 감소증 또는 혈소판 증가증 으로 구분할 수 있습니다. 혈소판 이상이 생기는 원인은 크게 두가지로 나눌 수 있는데 이는 혈소판 자체의 이상 또는 혈장 성분에 이상이 있을 수 있습니다.
어려운 말은 저도 여러분도 이해하기 힘들므로 전문용어로 하는 설명은 의사선생님께 맡기고, 이런 혈소판 이상으로 인해 나타나는 증상은 지혈 작용에의 문제입니다. 지혈 작용이 일어나지 않는 문제가 발생하게 됩니다. 특발성으로 혈소판이 증가하게 되면 혈전증, 색전증 이라는 위험한 합병증이 나타나기도 합니다.
혈소판 감소증 경우의 증상에는 쉽게 멍이 들기도 하고 자발성 잇몸출혈, 심한 코피, 월경과다 그리고 눌러도 사라지지 않는 붉은 점이나 피부얼룩이 나타납니다.

한마디로 혈소판 정상수치 벗어나 병이다, 질환이다 정도로 수치가 높아지면 혈관에 혈전이 생길 확률이 높아지고 수치가 낮아지면 출혈이 생기기 쉽다고 할 수 있습니다.
혈소판 증가증
정상수치가 15만에서 40만 또는 45만까지로 말해지고 있는데 이보다 많으면 기본적으로 혈소판 수치가 높다고 볼 수 있습니다. 저 또한 높을 때는 600이상이 나오기도 하고 항상 47만 이상의 수치가 나오고 있습니다. 하지만 이 정도로는 문제가 될만큼의 높은 수치는 아니라고 합니다.
비록 혈액검사에서 정상수치 벗어나 H로 표시되기는 하지만 우선은 크게 걱정을 하지 않아도 됩니다. 일반적으로 혈소판 증가증 이라고 하면 75만 이상의 수치가 나와야 합니다. 감기나 빈혈, 출혈 증상이 있다면 45만 이상이 나오는 경우는 흔한 편입니다.

혈소판 정상수치에서 높아지면 혈액응고가 잘되기 때문에 좋은 것이 아닐까 싶지만 너무 많으면 혈전이 생길 위험성이 높아집니다. 암, 철분결핍성 빈혈, 염증성 질환이 있다면 수치가 높게 나올 수 있습니다. 손가락끝이 화끈거리기도 하고 두통과 어지럼증, 흉통 및 숨가쁨 등의 증상이 나타날 수 있습니다.
혈소판 정상수치 벗어나 수치가 높다고 해도 대부분의 경우는 증상이 뚜렷하게 나타나지 않습니다. 증가증까지 올라가게 된다면 이는 혈액종양, 철분 부족, 염증 등의 2차적 요인이 원인이 될 수 있습니다. 그리고 혈소판 증가증 증상이 심하면 두통과 시각장애 그리고 비전형적인 가슴통증, 일과성 뇌허혈, 감각이상 등이 나타날 수 있습니다.


혈소판 감소증
정상수치인 15만보다 수치가 낮은 경우를 말합니다. 혈소판 수치가 1만~3만 정도라면 이는 자발적으로 출혈이 발생할 수 있으며 특히 1만 이하로 떨어진다면 이로 인해 생명이 위험할 수도 있습니다. 이런 자발적인 출혈은 수혈이 필요할 수 있으며 어떤 사고 등으로 다치면 사망 위험도가 높아집니다.
혈소판 감소증 경우는 바이러스나 약물의 부작용, 재생불량성 빈혈, 암, 자가면역질환, 화학치료부작용, 간경변, 만성출혈 등이 이 혈소판 감소증 원인이 될 수 있습니다.
혈소판 정상수치에서 벗어나 이렇게 수치가 낮으면 혈액응고가 제대로 제때에 이루어지지 않아서 과다출혈이 생길 수 있습니다. 또한 멍이 잘 들게 되며 자주색 피부반점 등이 나타납니다. 그리고 잇몸에 출혈이 있고 생리량이 많아지는 증상 등이 나타납니다.
혈소판 정상수치 및 증가증과 감소증 등 기준에서 벗어나면 어떤 증상 나타나는지를 알아보았는데요, 그 수치에 너무 민감해질 필요는 없지만 계속해서 수치에 이상이 있다면 의사선생님과의 상담을 해 보셔야 합니다.